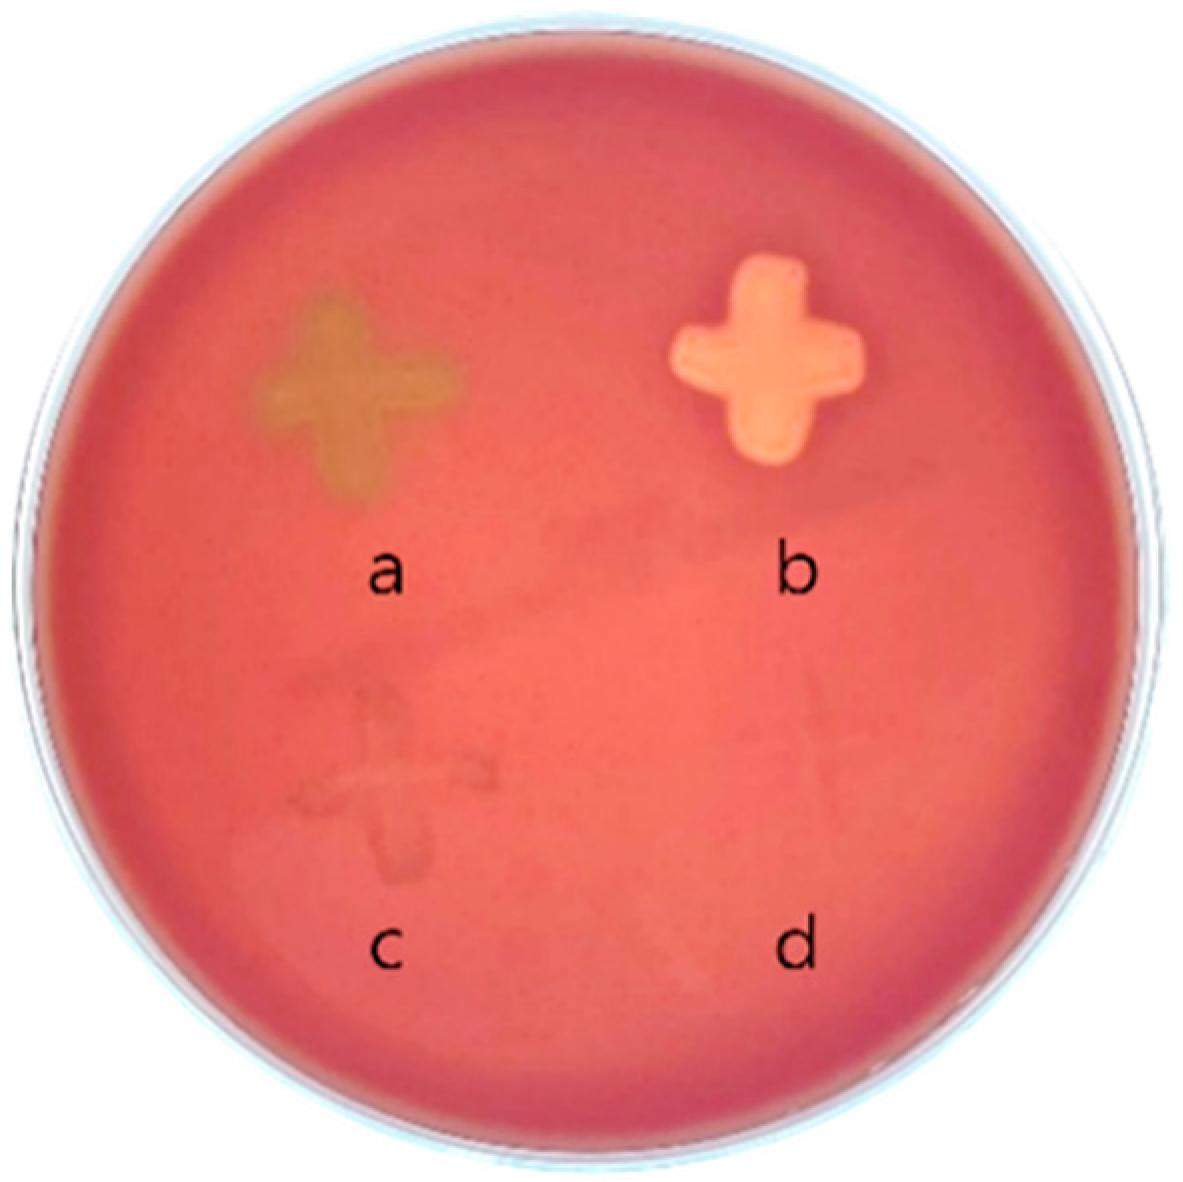
Microorganisms 13 02067 g001
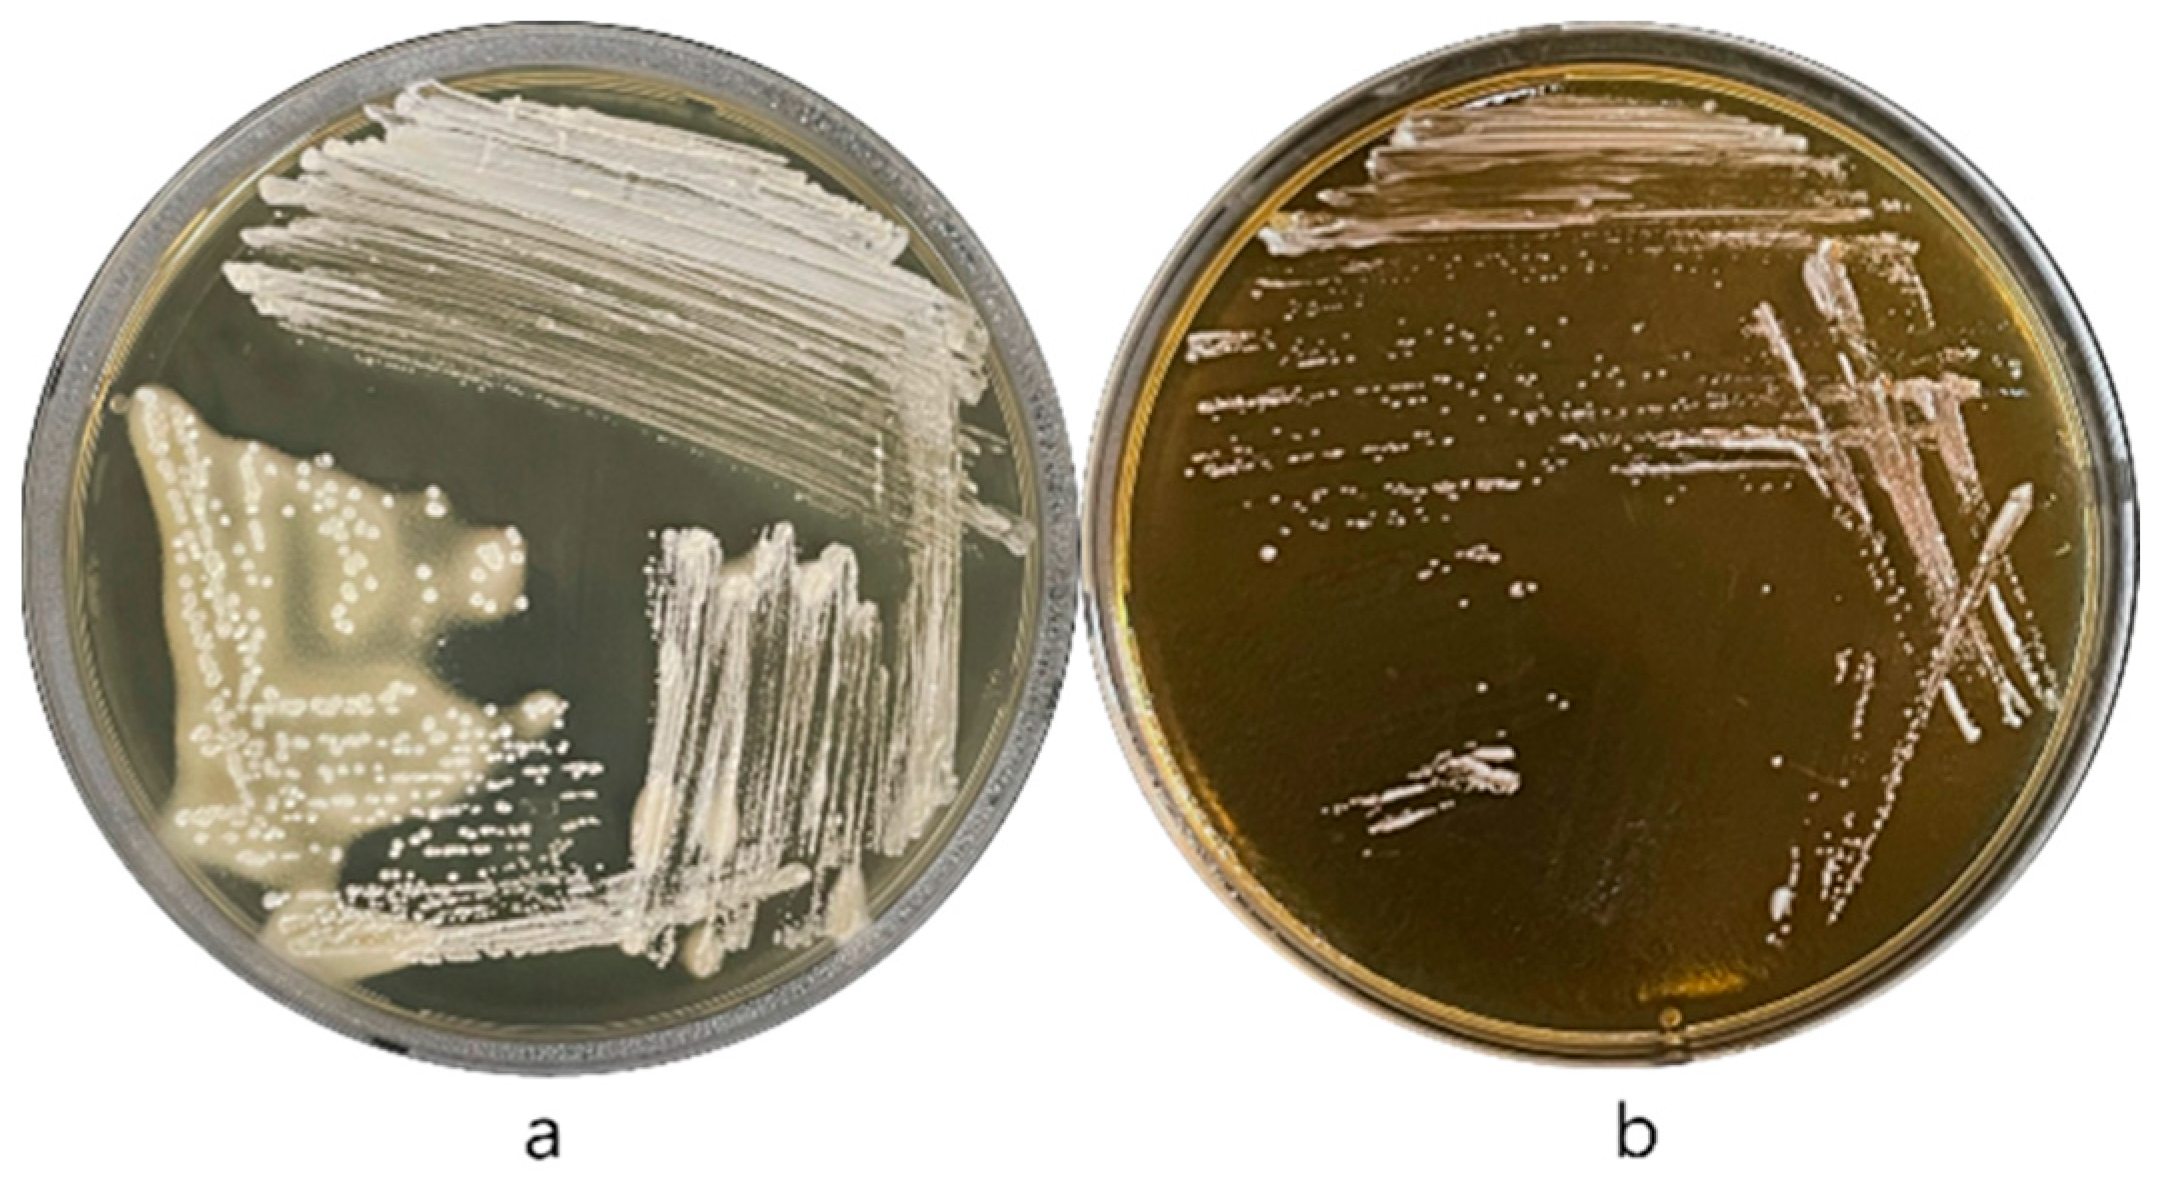
Microorganisms 13 02067 g002
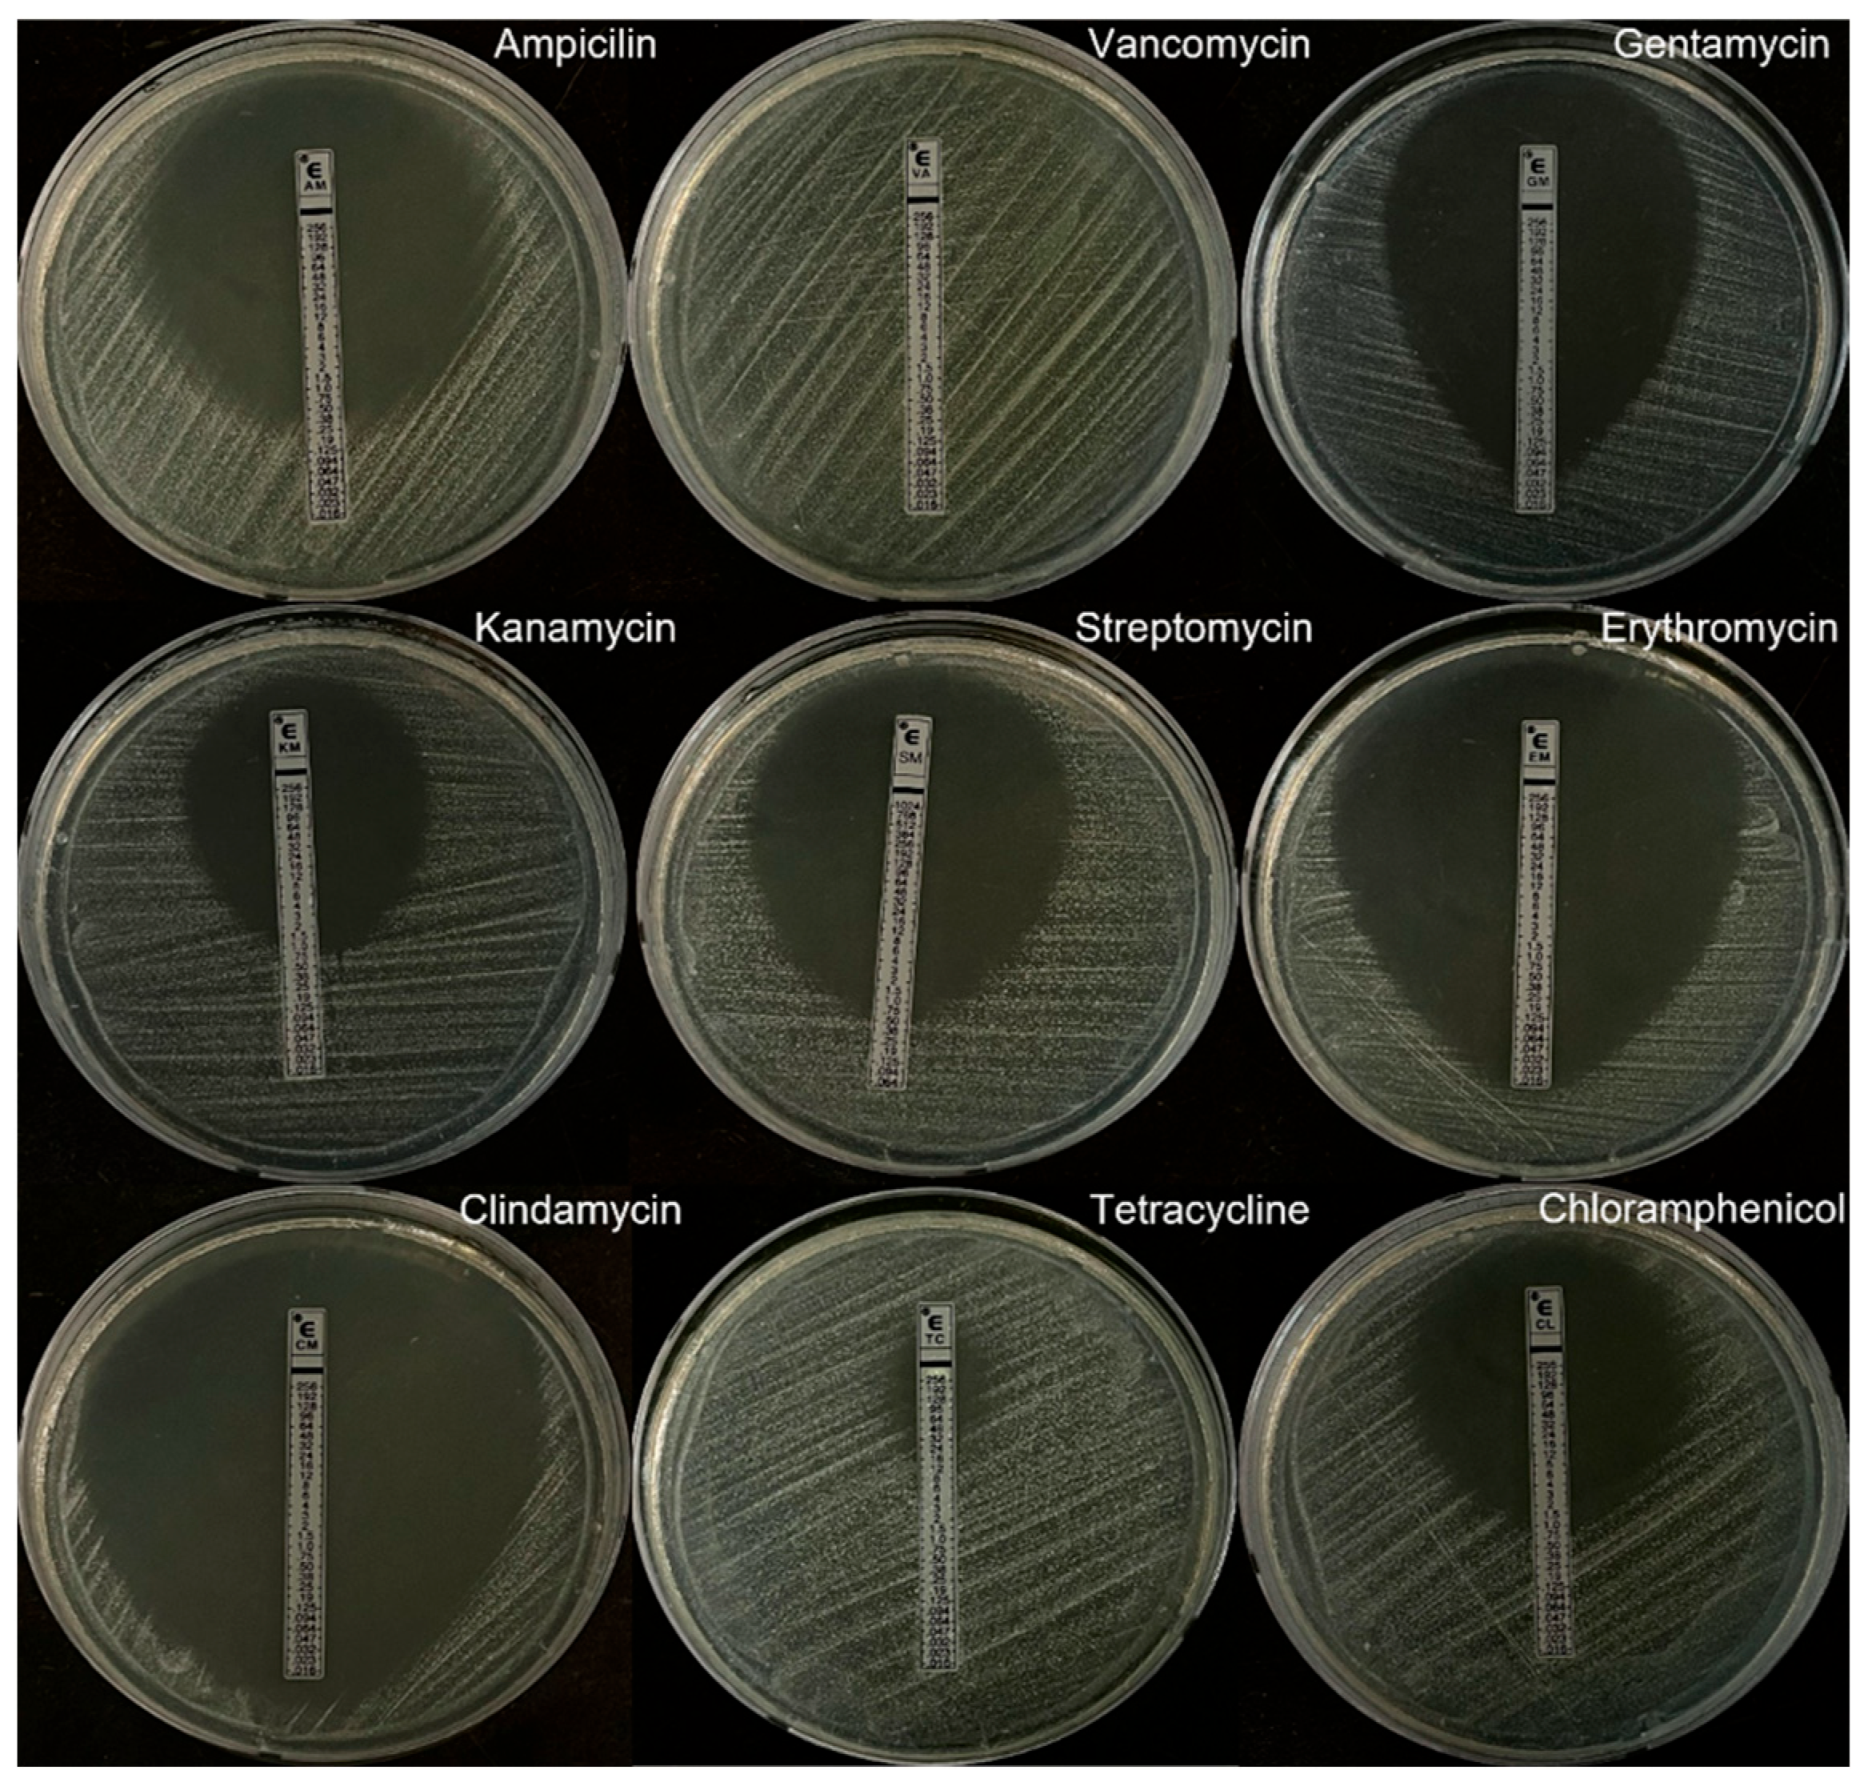
Microorganisms 13 02067 g005

Abstract
The safety profile of Lentilactobacillus buchneri KU200793, which has neuroprotective effects, was comprehensively evaluated through both phenotypic and genotypic analyses. Phenotypically, the strain exhibited no β-hemolysis, mucin degradation, indole production, gelatin liquefaction, urease activity, or β-glucuronidase activity. Additionally, it did not produce D-lactate, and only trace amounts of spermidine were detected among the biogenic amines. Furthermore, L. buchneri KU200793 did not exhibit bile salt deconjugation, further supporting its safety profile. However, its tetracycline resistance exceeded the threshold set by the European Food Safety Authority. Genotypic analysis using the HGTree program identified tetA(58) and nalD genes with sequence similarities of 33.64% and 30.17%, respectively, indicating a low level of homology. These findings suggest that tetracycline resistance in L. buchneri KU200793 is unlikely to have been acquired through horizontal gene transfer, thereby minimizing the risk of resistance gene dissemination. This study underscores the importance of comprehensive safety assessments to evaluate the suitability of L. buchneri KU200793 for probiotic applications.
1. Introduction
Lactic acid bacteria (LAB) have long been utilized as probiotics in dietary supplements and food products [1]. LAB serve not only as natural preservatives by enhancing the flavor and acidity of food but also offer various health benefits, including improving mucosal integrity, exhibiting anti-pathogenic properties, aiding in the management of lactose intolerance and food allergies, preventing diarrhea, and alleviating inflammation [2]. The Food and Agriculture Organization (FAO) and the World Health Organization (WHO) defined probiotics as “live microorganisms that, when administered in adequate amounts, confer a health benefit on the host” [3]. Traditionally, probiotics have been studied for their role in immune modulation and gut health. Recently, growing research into the causal links between microbiota and various diseases has increased interest in the therapeutic potential of probiotics for disease management [4,5].
Despite their potential health benefits, the expanding diversity of LAB and their increasing use as probiotics, particularly strains belonging to the genus Lactobacillus, have raised concerns regarding their safety [6,7]. A report by FAO and WHO highlights four potential adverse effects of probiotics: invasive infections, harmful metabolic processes, excessive immune activation in vulnerable individuals, and horizontal gene transfer (HGT) [8]. Furthermore, certain LAB are opportunistic pathogens linked to bacteremia, a rare but increasingly observed condition in patients with immune disorders or underlying health conditions. These concerns underscore the need for comprehensive safety assessments to ensure the safe use of LAB in food and dietary supplements [9].
Lentilactobacillus buchneri is an obligate heterofermentative, facultative anaerobic bacterium naturally found in diverse ecological environments and is closely associated with food production and fermentation processes [10]. This species is well-known for its beneficial effects, including the conversion of lactic acid to acetic acid, which inhibits the growth of certain yeasts and molds [11]. L. buchneri KU200793 exhibits various potential probiotic properties, including high resistance to artificial gastric juice and bile salts, cholesterol-lowering effects, and antimicrobial activity. Additionally, this strain demonstrates beneficial β-galactosidase activity and the absence of β-glucuronidase, indicating its safety. It also demonstrates remarkable antioxidant activity under heat-killed conditions. Furthermore, L. buchneri KU200793 has been shown to protect SH-SY5Y neuronal cells from MPP+-induced neurotoxicity by significantly enhancing cell viability and upregulating brain-derived neurotrophic factor (BDNF) mRNA expression. It also reduces the Bax/Bcl-2 ratio, thereby exerting an anti-apoptotic effect. These findings suggest that L. buchneri KU200793 possesses neuroprotective potential through the gut–brain axis and may serve as a promising probiotic candidate for the prevention of neurodegenerative diseases [12].
Although this strain was originally isolated from kimchi, a traditional fermented food, L. buchneri KU200793 has not been intentionally applied or evaluated for use in commercial food products or dietary supplements. Considering its potential application as a dietary supplement for humans, a comprehensive safety assessment is essential [13]. Accordingly, this study aimed to evaluate the safety of L. buchneri KU200793 based on the guidelines provided by the FAO/WHO (2002) and European Food Safety Authority (EFSA) [14].
2. Materials and Methods
2.1. Bacterial Strains and Culture Conditions
L. buchneri KU200793 (KCCM 12593P) was obtained from Konkuk University (Seoul, Republic of Korea) and grown anaerobically in de Man, Rogosa, and Sharpe broth (MRS; BD, Franklin Lakes, NJ, USA) at 37 °C for 24 h. The MRS broth contained (per liter): 10 g of protease peptone No. 3, 10 g of beef extract, 5 g of yeast extract, 20 g of dextrose, 1 g of polysorbate 80, 2 g of ammonium citrate, 5 g of sodium acetate, 0.1 g of magnesium sulfate, 0.05 g of manganese sulfate, and 2 g of dipotassium phosphate.
Klebsiella pneumoniae subsp. pneumoniae KCCM 60022, Proteus vulgaris KCCM 40221, Escherichia coli KCCM 11234, Streptococcus pneumoniae KCCM 41570, S. pyogenes KCCM 40411, S. agalactiae KCCM 40417, and Brevibacillus (Br.) parabrevis KCCM 41421 were purchased from the Korean Culture Center of Microorganisms (Seoul, Republic of Korea). Lactiplantibacillus plantarum KU15122 was obtained from Konkuk University (Seoul, Republic of Korea). Bacillus cereus KCCM 11204, K. pneumoniae subsp. pneumoniae KCCM 60022, P. vulgaris KCCM 40221, E. coli KCCM 11234, and Br. parabrevis KCCM 41421 were cultured in nutrient broth (BD) (3 g of beef extract and 5 g of peptone, per liter) at 30 °C for 24 h. Lp. plantarum KU15122 was cultured in MRS medium at 37 °C for 24 h.
2.2. Cell Culture Conditions
The Caco-2 cell line (ATCC® HTB-37™) was obtained from the American Type Culture Collection (ATCC, Manassas, VA, USA). Caco-2 cells are widely used as an in vitro model of intestinal epithelial cells in probiotic safety assessments, as their viability reflects the absence of cytotoxic effects. The cells were cultured in an incubator (Thermo Fisher Scientific, Waltham, MA, USA) maintained at 37 °C with 5% CO2. Dulbecco’s modified Eagle’s medium (DMEM; Gibco, Grand Island, NY, USA) supplemented with 1% (v/v) penicillin–streptomycin (Gibco), and 10% (v/v) fetal bovine serum (FBS; Corning Inc., Corning, NY, USA) was used as the culture medium.
2.3. Assessment of Hemolytic Activity
Hemolytic activity was evaluated by streaking bacteria on blood agar base No. 2 (Sigma-Aldrich, St. Louis, MO, USA) supplemented with 5% sheep blood (KisanBio, Seoul, Republic of Korea). The plates were inoculated with L. buchneri KU200793, S. pneumoniae KCCM 41570, S. pyogenes KCCM 40411 and S. agalactiae KCCM 40417 and then incubated under anaerobic conditions at 37 °C for 48 h. Strains that formed a green area around the colony were classified as α-hemolytic, those that formed a clear zone were classified as β-hemolytic, and those with no observable color change around the colony were classified as γ-hemolytic.
2.4. Evaluation of Bile Salt Deconjugation
Bile salt deconjugation was assessed using MRS containing 0.5% taurodeoxycholic acid (bile acid; Sigma-Aldrich). Plates inoculated with L. buchneri KU200793 and B. cereus KCCM 11204 were anaerobically cultured at 37 °C for 48 h. Strains with sedimentation around the bacterial colonies were classified as exhibiting bile salt hydrolase (BSH) activity.
2.5. Cytotoxicity Assay Using Caco-2 Cells
Caco-2 cells were seeded at a density of 5 × 104 cells/well in a 96-well plate in DMEM supplemented with 10% FBS and 1% penicillin–streptomycin. The cells were incubated at 37 °C in a 5% CO2 incubator for 20 h. L. buchneri KU200793 was cultured in MRS broth at 37 °C for 18 h, while K. pneumoniae subsp. pneumoniae KCCM 60022, used as a positive control, was grown in nutrient broth under the same conditions. Overnight cultures were inoculated into 10 mL of MRS medium at 37 °C for 7 h. Cells were harvested by centrifugation at 16,000× g for 1 min. The harvested cells were washed thrice with Dulbecco’s phosphate-buffered saline (DPBS; Welgene, Gyeongsan, Republic of Korea) and resuspended in 1 mL of DMEM containing 10% (v/v) FBS and 1% penicillin–streptomycin [15]. This suspension was added to Caco-2 cells at a multiplicity of infection (MOI; the ratio of LAB cells to Caco-2 cells) of 31.3, 62.5, and 125, and the cultures were incubated at 37 °C in a 5% CO2 incubator for 24 h. After 24 h, plates were washed twice with DPBS. Subsequently, 200 μL of DMEM containing 10% FBS and 1% penicillin–streptomycin was added to each well, followed by 20 μL of EZ-Cytox solution (DoGenBio Co., Ltd., Seoul, Republic of Korea). The mixture was incubated at 37 °C in a 5% CO2 atmosphere for 30 min. The EZ-Cytox assay utilizes water-soluble tetrazolium-8, which is reduced by intracellular dehydrogenases in viable cells to produce a water-soluble formazan dye. The amount of formazan formed is proportional to the metabolic activity of viable cells and thus serves as an indirect indicator of cytotoxicity [16]. Absorbance at 450 nm, reflecting cell viability through the amount of formazan produced, was measured using Take3 Micro-Volume Plates (Epoch Microplate Reader; BioTek Instruments, Inc., Winooski, VT, USA).
2.6. Determination of Mucin Degradation
L. buchneri KU200793 was inoculated into four types of media: a basal medium without any carbon source, a basal medium with 0.3% (w/v) mucin as the sole carbon source, a basal medium supplemented with 1% (w/v) glucose, and a basal medium containing both 0.3% (w/v) mucin and 1% (w/v) glucose. Bacterial growth was assessed after 8 and 24 h of incubation by measuring the optical density (OD) at 600 nm using a spectrophotometer (BioSpec-mini, Shimadzu Co., Kyoto, Japan) and by monitoring pH changes. Growth in mucin-containing media was considered to indicate the strain’s ability to utilize mucin as a carbon source, thereby reflecting potential mucin-degrading activity.
2.7. Quantification of D-Lactic Acid Production
The LAB culture was centrifuged at 16,000× g for 10 min, and the supernatant was collected. The obtained supernatant was analyzed using an Enzytec™ Liquid D-Lactic acid assay kit (R-Biopharm, Darmstadt, Germany) following the manufacturer’s instructions. The D-lactic acid concentration was determined by measuring absorbance at 340 nm using a BioSpec-mini spectrophotometer (Shimadzu Co.). This assay specifically detects D-lactic acid without cross-reactivity to L-lactic acid.
2.8. Analysis of Biogenic Amine Production
L. buchneri KU200793 was cultured in MRS medium supplemented with 400 ppm each of amino acid precursors, including ornithine, histidine, tryptophan, tyrosine, lysine, arginine, and phenylalanine (Sigma-Aldrich) at 37 °C for 20 h. One milliliter of the culture supernatant, 500 μL of saturated sodium carbonate solution, and 800 μL of 1% (w/v) dansyl chloride acetone solution were mixed and reacted at 45 °C for 1 h. Subsequently, 500 μL of 10% (w/v) proline and 5 mL of diethyl ether were added to the derivatized mixture, which was shaken for 10 min. The supernatant was collected and evaporated under nitrogen gas, then dissolved in 1 mL of acetonitrile and filtered through a 0.22 μm polyvinylidene difluoride filter. The derivatized biogenic amine (BA) mixture was quantitatively analyzed by high-performance liquid chromatography using a DIONEX UltiMate 3000 system (Thermo Fisher Scientific). The analysis was performed using a 250 × 4.6 mm, 5 μm, Agilent 5 TC-C18 column (Agilent Technologies, Amstelveen, The Netherlands) and a UV detector set at 254 nm, at a column oven temperature of 40 °C. Twenty microliters of the sample was injected into the column at 1 mL/min in a mobile phase consisting of 55:45 (acetonitrile–water) after equilibration for 30 min. The standard BAs evaluated in this study were agmatine, β-phenylethylamine, histamine, putrescine, serotonin, spermidine, tryptamine, and tyramine. To complement the phenotypic data, genes related to the polyamine transport system (potA–E) were identified by keyword searching annotated coding sequences in the L. buchneri KU200793 genome.
2.9. Antibiotic Susceptibility Test
The antibiotic susceptibility of L. buchneri KU200793 was assessed using E-test strips (ETEST, bioMérieux, Marcy-l’Étoile, France). The minimum inhibitory concentration (MIC) of each antibiotic was determined based on the cut-off values established by the EFSA for probiotics [14]. A suspension of bacterial colonies was prepared in 0.88% (w/v) NaCl solution and adjusted to match the 0.5 McFarland standard. This suspension was uniformly spread onto the surface of agar plates using sterile cotton swabs. E-test strips for antibiotics were placed on the agar surface using sterile forceps, and the plates were incubated at 37 °C for 24 h before evaluating the MIC.
2.10. Genomic Analysis of Antibiotic Resistance and Virulence Factors
The whole-genome sequence of L. buchneri KU200793 (NCBI Bioproject accession number: PRJNA1237560) was provided by Dankook University and was used to identify antibiotic resistance. The analysis was performed using Resistance Gene Identifier (RGI) software version 6.0.3 (https://card.mcmaster.ca/analyze/rgi, accessed on 18 February 2025) based on the Comprehensive Antibiotic Resistance Database version 3.2.8 and ResFinder version 4.4.1 (http://genepi.food.dtu.dk/resfinder, accessed on 4 March 2025) based on the ResFinder database. These tools were used to examine the presence of antibiotic resistance genes (ARGs) and assess the resistance levels associated with mutations. The criteria for RGI analysis included the following: Selection criteria: Perfect, Strict, and Loose hits; Nudge ≥ 95% identity for Loose hits to Strict (excluding nudge and low-confidence hits); and Sequence Quality: high quality/coverage. Loose hits were considered indicative of ARGs if they exhibited ≥70% sequence identity. For ResFinder analysis, the threshold criteria were set at 90% sequence similarity and a minimum length of 60%. Additionally, HGT potential was analyzed using the HGTree2 program, whereas the presence of ARGs within the plasmids and their potential for horizontal transfer were assessed using PlasmidFinder 2.0. PHASTEST was used to identify prophage regions within the genome to assess whether transduction was involved in the horizontal transfer of resistance genes. The involvement of transposons in HGT was assessed using MobileElementFinder.
2.11. Gelatin Liquefaction Assay
The gelatin liquefaction assay was conducted in MRS medium supplemented with 12% (w/v) gelatin. A single colony of L. buchneri KU200793 was introduced into the medium and incubated at 37 °C for 72 h. Br. parabrevis KCCM 41421 was used as a positive control and was incubated under identical conditions. After incubation, the test tubes were placed in an ice bath for 30 min. Strains capable of liquefying gelatin were considered positive for gelatinase activity.
2.12. Urease Activity Assay
The urease activity of bacterial cells was assessed by streaking them onto Christensen’s urea agar (0.1 g of peptone, 0.1 g of dextrose, 0.5 g of sodium chloride, 0.2 g of monopotassium phosphate, 2 g of urea, 0.012 g of phenol red) slants. L. buchneri KU200793 and P. vulgaris KCCM 40221, which was used as a positive control, were incubated at 37 °C for six days. Urease activity was determined by observing the changes in pH, as indicated by a color change in the slants from orange to pink. Pink coloration indicated ammonia production, confirming a positive urease reaction.
2.13. Indole Production Assay
Indole production was assessed using tryptophan as a substrate. L. buchneri KU200793 and E. coli KCCM 11234, used as a positive control, were cultured in tryptophan broth (10.0 g of casein enzyme hydrolysate, 5.0 g of NaCl, 1.0 g of DL-tryptophan, per liter) at 37 °C for 24 h. After incubation, five drops of Kovac reagent (Sigma-Aldrich) were added to the medium. A red ring on the surface of the medium indicated a positive result for indole production.
2.14. Statistical Analysis
All experiments were conducted in triplicate, with the results expressed as the mean ± standard deviation (SD). Statistical analyses were performed using SPSS 28 (SPSS Inc., Chicago, IL, USA) software. One-way analysis of variance (ANOVA) was used to evaluate the statistical significance of the results, and Duncan’s multiple range test was used to identify significant differences between groups. A p-value of <0.05 was considered statistically significant.
3. Results
3.1. Hemolytic Profile of L. buchneri KU200793
S. pneumoniae KCCM 41570 exhibited α-hemolysis, characterized by a greenish discoloration around the colonies on blood agar (Figure 1a). In contrast, the positive control, S. pyogenes KCCM 40411, displayed β-hemolysis, forming a clear hemolytic zone around the colonies (Figure 1b). S. agalactiae KCCM 40417 showed no hemolysis on blood agar, and the medium retained its red color (Figure 1c). Similarly, L. buchneri KU200793 exhibited no color change around its colonies, indicating the absence of hemolytic activity, and was thus classified as γ-hemolytic (Figure 1d).
Figure 1.
Hemolytic activity of bacterial strains. (a) S. pneumoniae KCCM 41570 (α-hemolysis); (b) S. pyogenes KCCM 40411 (β-hemolysis); (c) S. agalactiae KCCM 40417; and (d) L. buchneri KU200793 (γ-hemolysis).
3.2. Bile Salt Deconjugation Activity
Lp. plantarum KU15122 exhibited positive BSH activity, as indicated by the formation of a precipitation halo around the colonies due to bile salt deconjugation. Additionally, the agar appeared cloudy, and the colonies displayed a whitish, granular texture (Figure 2a). In contrast, L. buchneri KU200793 did not form any precipitate, confirming the absence of BSH activity (Figure 2b).
Figure 2.
Bile salt deconjugation test. (a) Lp. plantarum KU15122 (positive control) exhibited a precipitation halo, whereas (b) L. buchneri KU200793 showed no precipitate.
3.3. Cytotoxic Effects on Caco-2 Cells
L. buchneri KU200793 did not exhibit cytotoxicity under any of the tested MOI conditions. The positive control strain, K. pneumoniae subsp. pneumoniae KCCM 60022, showed cell viabilities of 64%, 58%, and 48% at MOI values of 31.3, 62.5, and 125, respectively. In contrast, L. buchneri KU200793 exhibited significantly higher cell viabilities of 146%, 133%, and 130%, respectively, under the same conditions, surpassing those of the untreated control group (Figure 3). These results clearly indicate that L. buchneri KU200793 is not cytotoxic and may even enhance cell viability under all tested MOI conditions.
Figure 3.
Effect of L. buchneri KU200793 on the cell viability of Caco-2 cells. Cells were treated with L. buchneri KU200793 (black bar) or K. pneumoniae subsp. pneumoniae KCCM 60022 (grey bar). Different letters indicate significant differences (p < 0.05).
3.4. Mucin Degradation Potential
L. buchneri KU200793 did not exhibit any increase in OD or pH changes in the medium containing 0.3% (w/v) mucin as the sole carbon source. In contrast, OD values increased in media containing glucose, which is commonly utilized as an optimal carbon source by most LAB (Figure 4). These results demonstrate that L. buchneri KU200793 does not exhibit mucin-degrading activity.
Figure 4.
Mucin degradation activity of L. buchneri KU200793. (a,b) Cell growth (OD600) at 8 h and 24 h; (c,d) culture pH at 8 h and 24 h. Different letters indicate significant differences (p < 0.05).
3.5. D-Lactic Acid Production Levels
The D-lactic acid production by L. buchneri KU200793 was quantified. The assay results showed that L. buchneri KU200793 produced 2 mM D-lactic acid (Table 1).
Table 1.
D-Lactic acid production of Lentilactobacillus buchneri KU200793.
3.6. Biogenic Amine Production Profile
Under our experimental conditions, the analysis of BA production in L. buchneri KU200793 revealed the presence of spermidine at a concentration of 15.27 ppm in the supernatant. However, no detectable levels of other Bas, such as agmatine, histamine, β-phenylethylamine, putrescine, serotonin, tyramine, and tryptamine were observed (Table 2).
Table 2.
Biogenic amine production of Lentilactobacillus buchneri KU200793.
3.7. Antibiotic Resistance Pattern
The antibiotic resistance of L. buchneri KU200793 was evaluated based on MIC values (μg/mL) exceeding the thresholds recommended by the EFSA. The results demonstrated that L. buchneri KU200793 was susceptible to all tested antibiotics, except for tetracycline (Figure 5, Table 3).
Figure 5.
E-test for the determination of antibiotic resistance.
Table 3.
Minimum inhibitory concentration and antibiotic susceptibility of Lentilactobacillus buchneri KU200793.
3.8. Genome-Based Identification of Resistance and Virulence Determinants
The complete genome sequence of L. buchneri KU200793 was analyzed to identify ARGs and assess the HGT potential. A total of 29 genes were predicted to have undergone HGT, of which 16 were identified as acquired genes and 13 as donated genes. Further analysis using HGTree2 and RGI confirmed that none of these predicted HGT-acquired genes contained ARGs. Additionally, PlasmidFinder 2.0 confirmed the absence of plasmids in L. buchneri KU200793. PHASTEST, which was used to evaluate the possibility of transduction, identified one intact prophage region. However, further analyses using RGI and ResFinder confirmed that no ARGs were present in the identified prophage region. The MobileElementFinder program identified eight mobile genetic elements, but ResFinder analysis did not detect any ARGs within these elements. Furthermore, RGI analysis identified tetA(58) with 33.64% homology and nalD with 30.17% homology (Table 4). The low-sequence homology suggested that these genes were unlikely to function as intact ARGs. Based on these results, we concluded that no functional ARGs were present within the intact prophage regions.
Table 4.
Results of antibiotic resistance gene analysis based on genome sequence data.
3.9. Gelatin Liquefaction Activity
No gelatin liquefaction was observed in the medium inoculated with L. buchneri KU200793. The medium remained solid, indicating that the strain does not produce enzymes capable of hydrolyzing gelatin. In contrast, the positive control strain, Br. parabrevis KCCM 41421, exhibited gelatin hydrolysis, resulting in liquefaction of the medium.
3.10. Urease Activity
The urease activity of L. buchneri KU200793 was assessed, and no color change was observed in the medium, indicating that the strain does not produce urease. In contrast, the positive control, P. vulgaris KCCM 40221, induced a color shift to pink, confirming urease activity and ammonia production.
3.11. Indole Production
L. buchneri KU200793 showed no observable changes in the surface layer after the addition of Kovac’s reagent, and no pink ring formation was detected, indicating that this strain did not produce indole. In contrast, the positive control strain, E. coli KCCM 11234, exhibited a distinct pink ring on the surface after the addition of Kovac’s reagent, suggesting tryptophanase activity, which enables the conversion of tryptophan to indole.
4. Discussion
Safety evaluation of probiotic strains is a crucial prerequisite for their commercial application and potential health benefits. Unverified strains present health risks, including opportunistic infections, HGT of antibiotic resistance, and harmful metabolic activities. Therefore, a comprehensive safety assessment—encompassing genome-based screening for ARGs, metabolic profiling, and both in vivo and in vitro toxicity evaluations—is essential. Only strains that meet rigorous safety standards should be considered for probiotic use. L. buchneri is listed in the EFSA’s Qualified Presumption of Safety (QPS) list, indicating its safety status for use in food and feed applications in the EU. This species-level recognition provides a basis for investigating the safety characteristics of strain L. buchneri KU200793.
Hemolytic activity is a key parameter in probiotic safety evaluation, as β-hemolysis is associated with pathogenic potential. Using blood agar assays, L. buchneri KU200793 exhibited no hemolytic activity, consistent with the γ-hemolytic phenotype. The absence of hemolytic activity indicates non-pathogenic properties in probiotic strains and serves as a positive indicator in their safety assessment [17]. Consistent with our findings, a previous study reported no β-hemolytic activity in four other Lactobacillus strains, including L. fermentum IDCC 3901 [18].
BSH is widely present in the gut microbiota and contributes to microbial survival, but its activity may generate harmful secondary bile acids linked to adverse health effects [19,20]. Owing to the potential risks associated with BSH activity, the Ministry of Food and Drug Safety of Korea recommends cautionary labeling for probiotics with positive BSH activity to prevent excessive consumption. The findings of this study confirm that L. buchneri KU200793 is a safe strain with no BSH activity. These results align with those of a previous study reporting the absence of BSH activity in L. paracasei subsp. paracasei NTU101 [8].
L. buchneri KU200793 enhanced the survival of Caco-2 cells, which are widely used as an intestinal epithelial model for probiotic safety assessment. Cell viability was assessed using a colorimetric assay with water-soluble tetrazolium-8. The amount of formazan produced correlates with the metabolic activity of viable cells, thereby indirectly reflecting cell viability. These findings provide scientific evidence supporting the safety of L. buchneri KU200793 and reinforce previous reports that probiotic strains are not expected to be cytotoxic to intestinal epithelial cells [21].
The intestinal mucus layer provides both a favorable niche for microbial survival and a primary barrier against pathogen and toxin entry. Mucin degradation, a known virulence trait of pathogens such as Vibrio cholerae, Helicobacter pylori, Salmonella, Shigella, and Staphylococcus aureus, facilitates host invasion and increases susceptibility to harmful compounds [22,23]. This study aligns with previous research reporting that L. rhamnosus HN001, L. acidophilus HN017, and Bifidobacterium lactis HN019 do not exhibit mucin-degradation activity [24]. Similarly, an earlier study found that none of the 75 tested Lactococcus lactis strains exhibited mucin-degrading activity [25].
In contrast to L-lactic acid, which is efficiently metabolized in humans, D-lactic acid is produced in a strain- and condition-dependent manner and undergoes only limited degradation by intestinal enzymes [26]. Consequently, the excessive consumption of probiotics that produce D-lactic acid can lead to its accumulation in the bloodstream, potentially resulting in D-lactic acidosis. In healthy adults, blood D-lactic acid levels typically range from 5 to 20 μmol/L, which is considered safe [27]. However, when the concentration exceeds 3 mmol/L, D-lactic acidosis may occur, causing various neurological symptoms [28]. The production levels of D-lactic acid vary depending on the type of probiotic strain, and L. buchneri, which belongs to the Lentilactobacillus genus, is known to produce both D- and L-lactic acid, classifying it as a D, L-lactate-producing strain [29]. L. buchneri KU200793 demonstrated a relatively low level of D-lactic acid production, highlighting its safety attributes as a probiotic strain. The amount of D-lactic acid produced by this strain was significantly lower than that produced by L. lactis DSM20072, which produces 7.47 mM [30], and L. rhamnosus GG, a widely used commercial probiotic strain [26].
BAs produced via amino acid decarboxylation are well known to act as neurotransmitters in humans, and spermidine, an endogenous metabolite, additionally plays a crucial role in cell growth, anti-aging, and autophagy [31]. Fermented and long-stored foods often show elevated BA levels due to microbial contamination, and some Lactobacillus species are major BA producers that generate them under acidic conditions as a survival strategy [32,33]. However, excessive BA accumulation may cause adverse effects such as headaches, neurological disorders, or hypotension, and high intake of histamine and tyramine has been linked to histamine poisoning and hypertensive crisis [34].
The spermidine production in L. buchneri KU200793 was relatively low compared with that in previously reported probiotic strains, such as L. brevis NZ.Lbr.082 and L. paracasei NZ.Lbp.105, which produced 23.06 and 35.81 ppm of spermidine, respectively [35]. Although these strains are not phylogenetically closest to L. buchneri, they are commonly used probiotic lactobacilli with established safety profiles and functional similarities, particularly in fermented food contexts [36]. Therefore, the comparison provides a relevant benchmark indicating that the BA production of L. buchneri KU200793 remains within a safe and acceptable range. Furthermore, fermented soybean-based foods contain high concentrations of BAs and BA-producing microorganisms. According to the literature, the maximum BA concentrations reported in fermented products such as soy sauce, natto, and cheonggukjang were 53.1 ppm, 478.1 ppm, and 79.1 ppm, respectively, indicating that the BA levels present in typical dietary intake are higher than those produced by L. buchneri KU200793. In addition, no specific dietary intake recommendations or toxicity thresholds have been established for putrescine, spermidine, or tryptamine in healthy individuals, suggesting that their consumption is not strictly regulated. Moreover, the regulatory authorities in various countries have not set specific permissible limits for spermidine, further supporting its safety [37].
In nature, antibiotics function as competitive tools among microorganisms, but their indiscriminate use has accelerated the emergence of antimicrobial resistance in both pathogenic and commensal species [38]. LAB, including Lactobacillus species, are generally considered safe. However, concerns regarding antibiotic resistance in LAB have emerged following reports of antibiotic-resistant Lactobacillus strains isolated from cheese [39]. The acquisition of antibiotic resistance reduces treatment efficacy, and the potential transfer of ARGs from probiotics to pathogens represents a critical public health concern. Therefore, assessing the antibiotic resistance profiles of probiotic strains before they can be used for food applications is essential [40]. In the present study, L. buchneri KU200793 exhibited tetracycline resistance; however, its overall antibiotic resistance levels were lower than those previously reported for other probiotic strains. L. salivarius CGMCC2070 showed resistance to both tetracycline and erythromycin as well as intermediate resistance to gentamicin [41]. In addition, five L. lactis strains demonstrated resistance to both tetracycline and streptomycin [42]. Compared with previously reported strains that exhibit resistance to multiple antibiotics, L. buchneri KU200793 appears to be a relatively safer probiotic candidate regarding antibiotic resistance. However, further investigations are required to clarify the mechanisms and genomic context of tetracycline resistance, for which we conducted in silico analysis based on whole-genome sequencing data.
Antibiotic resistance can arise either intrinsically, through mutations stably inherited within a strain, or via HGT, which poses a greater risk due to the possibility of ARG dissemination to pathogens [43,44]. Plasmid conjugation, whereby a donor strain transfers a plasmid to a recipient through pilus-mediated contact, represents a major HGT mechanism [45]. Transduction by bacteriophages and mobilization of transposons further contribute to ARG transfer, and integration of resistance-associated transposons into plasmids can accelerate ARG dissemination among bacterial populations [46,47]. Genome analysis confirmed the absence of exogenous resistance determinants commonly associated with HGT, indicating that the tetracycline resistance in L. buchneri KU200793 is intrinsic rather than acquired. This result suggests that the strain has a minimal potential for ARG dissemination via horizontal gene transfer.
Gelatinase is a biologically active protease that degrades host proteins such as collagen, casein, and hemoglobin, and its activity has been implicated in bacterial pathogenesis, tissue damage, and the progression of inflammatory diseases such as endocarditis [24,48]. In addition, gelatinase can modulate host factors including cytokines and growth factors, functioning as a virulence determinant in pathogenic bacteria, while bacterial metalloproteinases have also been linked to infection processes and tumor progression [49]. In this study, L. buchneri KU200793 showed no gelatin liquefaction, indicating the absence of gelatinase activity and supporting its safety by excluding this virulence-associated trait.
Urease is a nickel-dependent metalloenzyme that hydrolyzes urea into carbon dioxide and ammonia, and its activity has been implicated in urinary tract infections, hepatic encephalopathy, and other pathological conditions [50,51]. Moreover, in H. pylori, urease contributes to acid resistance but also causes cytotoxic damage to gastric epithelial cells through ammonia production. In this study, L. buchneri KU200793 showed no detectable urease activity, supporting its safety by excluding this virulence-associated trait.
Indole is a nitrogen-containing metabolite generated by microbial tryptophan metabolism via tryptophanase and has been associated with neurotoxic and metabolic effects, including impaired motor function, anxiety, and depression [52]. Once absorbed, indole is converted to indoxyl sulfate in the liver, which induces nephrotoxicity and has been reported at elevated levels in patients with Parkinson’s disease [52,53]. In this study, L. buchneri KU200793 did not produce indole, consistent with previous findings that none of the tested Lactobacillus strains exhibited this activity [54].
5. Conclusions
A comprehensive safety assessment of L. buchneri KU200793 demonstrated its potential as a safe probiotic strain. The absence of harmful enzymatic activities, the low production of detrimental metabolites, and the lack of cytotoxicity in Caco-2 cells collectively support its safety. Although tetracycline resistance was detected, genome analysis indicated that this trait is intrinsic and unlikely to be transferred horizontally, minimizing concerns about ARG dissemination. In addition to the previously reported neuroprotective properties of this strain, the present study established its safety, thereby reinforcing the feasibility of its use in food applications and probiotic supplementation. Overall, these findings highlight the importance of rigorous safety evaluations to ensure the responsible development of probiotics and support the potential utilization of L. buchneri KU200793 as a safe candidate for incorporation into dietary products.
Author Contributions
Conceptualization, D.-K.K., H.-D.P., Y.-S.P. and J.H.L.; methodology, S.K., N.-K.L., Y.-S.P. and J.H.L.; software, S.K., H.J. and N.-K.L.; validation, S.K., H.J. and N.-K.L.; formal analysis, S.K.; investigation, S.K., H.J., N.-K.L., Y.-S.P. and J.H.L.; resources, D.-K.K., H.-D.P., Y.-S.P. and J.H.L.; data curation, S.K. and H.J.; writing—original draft preparation, S.K. and H.J.; writing—review and editing, Y.-S.P. and J.H.L.; visualization, S.K.; supervision, Y.-S.P. and J.H.L.; project administration, Y.-S.P. and J.H.L.; funding acquisition, H.-D.P. and J.H.L. All authors have read and agreed to the published version of the manuscript.
Funding
This research was funded by the Gachon University research fund of 2024 (GCU-202406430001) and the Korea Institute of Planning and Evaluation for Technology in Food, Agriculture, and Forestry (IPET) through the High Value-Added Food Technology Development Program funded by the Ministry of Agriculture, Food, and Rural Affairs (MAFRA) (grant number 321035052HD020).
Institutional Review Board Statement
Not applicable.
Informed Consent Statement
Not applicable.
Data Availability Statement
The original contributions presented in this study are included in the article. Further inquiries can be directed to the corresponding authors.
Acknowledgments
The authors acknowledge the support provided by the Gachon University Research Fund of 2024 (GCU-202406430001) and the Korea Institute of Planning and Evaluation for Technology in Food, Agriculture, and Forestry (IPET) through the High Value-Added Food Technology Development Program funded by the Ministry of Agriculture, Food, and Rural Affairs (MAFRA) (grant number 321035052HD020).
Conflicts of Interest
The authors declare no conflicts of interest.
References
- Koll, P.; Mändar, R.; Smidt, I.; Hütt, P.; Truusalu, K.; Mikelsaar, R.H.; Shchepetova, J.; Krogh-Andersen, K.; Marcotte, H.; Hammarström, L.; et al. Screening and evaluation of human intestinal lactobacilli for the development of novel gastrointestinal probiotics. Curr. Microbiol. 2010, 61, 560–566. [Google Scholar] [CrossRef]
- Gemechu, T. Review on lactic acid bacteria function in milk fermentation and preservation. Afr. J. Food Sci. 2015, 9, 170–175. [Google Scholar] [CrossRef]
- FAO/WHO. Guidelines for the Evaluation of Probiotics in Food; FAO/WHO Working Group; FAO: Rome, Italy; WHO: Geneva, Switzerland, 2002; pp. 1–11. [Google Scholar]
- Barrea, L.; Verde, L.; Auriemma, R.S.; Vetrani, C.; Cataldi, M.; Frias-Toral, E.; Pugliese, G.; Camajani, E.; Savastano, S.; Colao, A.; et al. Probiotics and prebiotics: Any role in menopause-related diseases? Curr. Nutr. Rep. 2023, 12, 83–97. [Google Scholar] [CrossRef]
- Chon, J.W.; Youn, H.Y.; Kim, H.J.; Oh, H.; Kang, S.H.; Hwang, W.U.; Jeong, H.; Kim, H.J.; Seo, K.H.; Song, K.Y. Anti-viral activities of probiotics against viral gastroenteritis: A review. J. Dairy Sci. Biotechnol. 2023, 41, 87–102. [Google Scholar] [CrossRef]
- Lee, B.S.; Ban, O.H.; Bang, W.Y.; Chae, S.A.; Oh, S.; Park, C.; Lee, M.; Kim, S.J.; Yang, J.; Jung, Y.H. Safety assessment of Lactobacillus reuteri IDCC 3701 based on phenotypic and genomic analysis. Ann. Microbiol. 2021, 71, 10. [Google Scholar] [CrossRef]
- Sarita, B.; Samadhan, D.; Hassan, M.Z.; Kovaleva, E.G. A comprehensive review of probiotics and human health—Current prospective and applications. Front. Microbiol. 2025, 15, 1487641. [Google Scholar] [CrossRef] [PubMed]
- Chen, C.T.; Chao, W.Y.; Lin, C.H.; Shih, T.W.; Pan, T.M. Comprehensive safety assessment of Lacticaseibacillus paracasei subsp. paracasei NTU 101 through integrated genotypic and phenotypic analysis. Curr. Issues Mol. Biol. 2024, 46, 12354–12374. [Google Scholar] [CrossRef] [PubMed]
- Lee, M.; Bang, W.Y.; Lee, H.B.; Yang, S.Y.; Lee, K.S.; Kang, H.J.; Hong, S.M.; Yang, J. Safety assessment and evaluation of probiotic potential of Lactobacillus bulgaricus IDCC 3601 for human use. Microorganisms 2024, 12, 2063. [Google Scholar] [CrossRef]
- Nethery, M.A.; Henriksen, E.D.; Daughtry, K.V.; Johanningsmeier, S.D.; Barrangou, R. Comparative genomics of eight Lactobacillus buchneri strains isolated from food spoilage. BMC Genom. 2019, 20, 902. [Google Scholar] [CrossRef]
- Heinl, S.; Wibberg, D.; Eikmeyer, F.; Szczepanowski, R.; Blom, J.; Linke, B.; Goesmann, A.; Grabherr, R.; Schwab, H.; Pühler, A.; et al. Insights into the completely annotated genome of Lactobacillus buchneri CD034, a strain isolated from stable grass silage. J. Biotechnol. 2012, 161, 153–166. [Google Scholar] [CrossRef]
- Cheon, M.J.; Lim, S.M.; Lee, N.K.; Paik, H.D. Probiotic properties and neuroprotective effects of Lactobacillus buchneri KU200793 isolated from Korean fermented foods. Int. J. Mol. Sci. 2020, 21, 1227. [Google Scholar] [CrossRef]
- Shokryazdan, P.; Faseleh Jahromi, M.; Liang, J.B.; Kalavathy, R.; Sieo, C.C.; Ho, Y.W. Safety assessment of two new Lactobacillus strains as probiotic for human using a rat model. PLoS ONE 2016, 11, e0159851. [Google Scholar] [CrossRef]
- EFSA Panel on Additives and Products or Substances used in Animal Feed (FEEDAP); Rychen, G.; Aquilina, G.; Azimonti, G.; Bampidis, V.; Bastos, M.L.; Bories, G.; Chesson, A.; Cocconcelli, P.S.; Flachowsky, G.; et al. Guidance on the characterisation of microorganisms used as feed additives or as production organisms. EFSA J. 2018, 16, e05206. [Google Scholar] [CrossRef]
- Lee, M.G.; Kang, M.J.; Kim, S.; Jeong, H.; Kang, D.K.; Paik, H.D.; Park, Y.S. Safety assessment of Levilactobacillus brevis KU15006: A comprehensive analysis of its phenotypic and genotypic properties. Probiotics Antimicrob. Proteins 2024, 17, 1117–1131. [Google Scholar] [CrossRef]
- Tail, M.; Zhang, H.; Zheng, G.; Hatami, M.; Skutella, T.; Unterberg, A.; Zweckberger, K.; Younsi, A. The sonic hedgehog pathway modulates survival, proliferation, and differentiation of neural progenitor cells under inflammatory stress in vitro. Cells 2022, 11, 736. [Google Scholar] [CrossRef]
- Kim, T.; Mondal, S.C.; Jeong, C.R.; Kim, S.R.; Ban, O.H.; Jung, Y.H.; Yang, J.; Kim, S.J. Safety evaluation of Lactococcus lactis IDCC 2301 isolated from homemade cheese. Food Sci. Nutr. 2022, 10, 67–74. [Google Scholar] [CrossRef]
- Lee, Y.R.; Bang, W.Y.; Baek, K.R.; Kim, G.H.; Kang, M.J.; Yang, J.; Seo, S.O. Safety evaluation by phenotypic and genomic characterization of four Lactobacilli strains with probiotic properties. Microorganisms 2022, 10, 2218. [Google Scholar] [CrossRef]
- Bourgin, M.; Kriaa, A.; Mkaouar, H.; Mariaule, V.; Jablaoui, A.; Maguin, E.; Rhimi, M. Bile salt hydrolases: At the crossroads of microbiota and human health. Microorganisms 2021, 9, 1122. [Google Scholar] [CrossRef]
- Costarelli, V.; Key, T.; Appleby, P.; Allen, D.; Fentiman, I.; Sanders, T. A prospective study of serum bile acid concentrations and colorectal cancer risk in post-menopausal women on the island of Guernsey. Br. J. Cancer 2002, 86, 1741–1744. [Google Scholar] [CrossRef][Green Version]
- Joung, H.; Chu, J.; Kwon, Y.J.; Kim, K.H.; Shin, C.H.; Ha, J.H. Assessment of the safety and hepatic lipid-lowering effects of Lactobacillus delbrueckii subsp. lactis CKDB001. Appl. Biol. Chem. 2024, 67, 101. [Google Scholar] [CrossRef]
- Pradhan, D.; Singh, R.; Tyagi, A.; Rashmi, H.; Batish, V.; Grover, S. Assessing safety of Lactobacillus plantarum MTCC 5690 and Lactobacillus fermentum MTCC 5689 using in vitro approaches and an in vivo murine model. Regul. Toxicol. Pharmacol. 2019, 101, 1–11. [Google Scholar] [CrossRef]
- Varada, V.V.; Panneerselvam, D.; Pushpadass, H.A.; Mallapa, R.H.; Ram, C.; Kumar, S. In vitro safety assessment of electrohydrodynamically encapsulated Lactiplantibacillus plantarum CRD7 and Lacticaseibacillus rhamnosus CRD11 for probiotics use. Curr. Res. Food Sci. 2023, 6, 100507. [Google Scholar] [CrossRef]
- Zhou, J.; Gopal, P.; Gill, H. Potential probiotic lactic acid bacteria Lactobacillus rhamnosus (HN001), Lactobacillus acidophilus (HN017) and Bifidobacterium lactis (HN019) do not degrade gastric mucin in vitro. Int. J. Food Microbiol. 2001, 63, 81–90. [Google Scholar] [CrossRef]
- Araújo, C.; Munoz-Atienza, E.; Ramírez, M.; Poeta, P.; Igrejas, G.; Hernández, P.E.; Herranz, C.; Cintas, L.M. Safety assessment, genetic relatedness and bacteriocin activity of potential probiotic Lactococcus lactis strains from rainbow trout (Oncorhynchus mykiss, Walbaum) and rearing environment. Eur. Food Res. Technol. 2015, 241, 647–662. [Google Scholar] [CrossRef]
- Song, E.J.; Lee, E.S.; Kim, Y.I.; Shin, D.U.; Eom, J.E.; Shin, H.S.; Lee, S.Y.; Nam, Y.D. Gut microbial change after administration of Lacticaseibacillus paracasei AO356 is associated with anti-obesity in a mouse model. Front. Endocrinol. 2023, 14, 1224636. [Google Scholar] [CrossRef]
- Łukasik, J.; Salminen, S.; Szajewska, H. Rapid review shows that probiotics and fermented infant formulas do not cause d-lactic acidosis in healthy children. Acta Paediatr. 2018, 107, 1322–1326. [Google Scholar] [CrossRef]
- Uchida, H.; Yamamoto, H.; Kisaki, Y.; Fujino, J.; Ishimaru, Y.; Ikeda, H. D-lactic acidosis in short-bowel syndrome managed with antibiotics and probiotics. J. Pediatr. Surg. 2004, 39, 634–636. [Google Scholar] [CrossRef]
- Jang, Y.J.; Gwon, H.M.; Jeong, W.S.; Yeo, S.H.; Kim, S.Y. Safety evaluation of Weissella cibaria JW15 by phenotypic and genotypic property analysis. Microorganisms 2021, 9, 2450. [Google Scholar] [CrossRef]
- Stuivenberg, G.; Daisley, B.; Akouris, P.; Reid, G. In vitro assessment of histamine and lactate production by a multi-strain synbiotic. J. Food Sci. Technol. 2021, 59, 3419–3427. [Google Scholar] [CrossRef]
- Kim, M.J.; Ku, S.; Kim, S.Y.; Lee, H.H.; Jin, H.; Kang, S.; Li, R.; Johnston, T.V.; Park, M.S.; Ji, G.E. Safety evaluations of Bifidobacterium bifidum BGN4 and Bifidobacterium longum BORI. Int. J. Mol. Sci. 2018, 19, 1422. [Google Scholar] [CrossRef]
- Capozzi, V.; Russo, P.; Ladero, V.; Fernández, M.; Fiocco, D.; Alvarez, M.A.; Grieco, F.; Spano, G. Biogenic amines degradation by Lactobacillus plantarum: Toward a potential application in wine. Front. Microbiol. 2012, 3, 122. [Google Scholar] [CrossRef]
- Bin Hafeez, A.; Pełka, K.; Worobo, R.; Szweda, P. In silico safety assessment of Bacillus isolated from polish bee pollen and bee bread as novel probiotic candidates. Int. J. Mol. Sci. 2024, 25, 666. [Google Scholar] [CrossRef]
- Ku, S.; Yang, S.; Lee, H.H.; Choe, D.; Johnston, T.V.; Ji, G.E.; Park, M.S. Biosafety assessment of Bifidobacterium animalis subsp. lactis AD011 used for human consumption as a probiotic microorganism. Food Control 2020, 117, 106985. [Google Scholar] [CrossRef]
- Yilmaz, N. Quantitative analysis of biogenic amine production of different lactic acid bacteria isolated from ready-to-eat packaged fish products. Vet. Res. Forum 2024, 15, 537–543. [Google Scholar] [CrossRef]
- Chen, T.; Zhao, Y.; Fan, Y.; Dong, Y.; Gai, Z. Genome sequence and evaluation of safety and probiotic potential of Lacticaseibacillus paracasei LC86 and Lacticaseibacillus casei LC89. Front. Microbiol. 2025, 15, 1501502. [Google Scholar] [CrossRef]
- Turna, N.S.; Chung, R.; McIntyre, L. A review of biogenic amines in fermented foods: Occurrence and health effects. Heliyon 2024, 10, e24501. [Google Scholar] [CrossRef]
- Rajasekaran, J.J.; Krishnamurthy, H.K.; Bosco, J.; Jayaraman, V.; Krishna, K.; Wang, T.; Bei, K. Oral microbiome: A review of its impact on oral and systemic health. Microorganisms 2024, 12, 1797. [Google Scholar] [CrossRef]
- Coppola, R.; Succi, M.; Tremonte, P.; Reale, A.; Salzano, G.; Sorrentino, E. Antibiotic susceptibility of Lactobacillus rhamnosus strains isolated from parmigiano reggiano cheese. Lait 2005, 85, 193–204. [Google Scholar] [CrossRef]
- Imperial, I.C.; Ibana, J.A. Addressing the antibiotic resistance problem with probiotics: Reducing the risk of its double-edged sword effect. Front. Microbiol. 2016, 7, 1983. [Google Scholar] [CrossRef] [PubMed]
- Jiang, Y.H.; Yang, R.S.; Lin, Y.C.; Xin, W.G.; Zhou, H.Y.; Wang, F.; Zhang, Q.L.; Lin, L.B. Assessment of the safety and probiotic characteristics of Lactobacillus salivarius CGMCC20700 based on whole-genome sequencing and phenotypic analysis. Front. Microbiol. 2023, 14, 1120263. [Google Scholar] [CrossRef]
- Kondrotiene, K.; Lauciene, L.; Andruleviciute, V.; Kasetiene, N.; Serniene, L.; Sekmokiene, D.; Malakauskas, M. Safety assessment and preliminary in vitro evaluation of probiotic potential of Lactococcus lactis strains naturally present in raw and fermented milk. Curr. Microbiol. 2020, 77, 3013–3023. [Google Scholar] [CrossRef] [PubMed]
- Colautti, A.; Arnoldi, M.; Comi, G.; Iacumin, L. Antibiotic resistance and virulence factors in lactobacilli: Something to carefully consider. Food Microbiol. 2022, 103, 103934. [Google Scholar] [CrossRef]
- de Niederhäusern, S.; Bondi, M.; Messi, P.; Iseppi, R.; Sabia, C.; Manicardi, G.; Anacarso, I. Vancomycin-resistance transferability from VanA enterococci to Staphylococcus aureus. Curr. Microbiol. 2011, 62, 1363–1367. [Google Scholar] [CrossRef]
- van Reenen, C.A.; Dicks, L.M. Horizontal gene transfer amongst probiotic lactic acid bacteria and other intestinal microbiota: What are the possibilities? A review. Arch. Microbiol. 2011, 193, 157–168. [Google Scholar] [CrossRef]
- Im, E.J.; Lee, H.H.Y.; Kim, M.; Kim, M.K. Evaluation of enterococcal probiotic usage and review of potential health benefits, safety, and risk of antibiotic-resistant strain emergence. Antibiotics 2023, 12, 1327. [Google Scholar] [CrossRef]
- Mathur, S.; Singh, R. Antibiotic resistance in food lactic acid bacteria—A review. Int. J. Food Microbiol. 2005, 105, 281–295. [Google Scholar] [CrossRef]
- Zhang, F.; Jiang, M.; Wan, C.; Chen, X.; Chen, X.; Tao, X.; Shah, N.P.; Wei, H. Screening probiotic strains for safety: Evaluation of virulence and antimicrobial susceptibility of enterococci from healthy Chinese infants. J. Dairy Sci. 2016, 99, 4282–4290. [Google Scholar] [CrossRef] [PubMed]
- Mortezaei, M.; Dadmehr, M.; Korouzhdehi, B.; Hakimi, M.; Ramshini, H. Colorimetric and label free detection of gelatinase positive bacteria and gelatinase activity based on aggregation and dissolution of gold nanoparticles. J. Microbiol. Methods 2021, 191, 106349. [Google Scholar] [CrossRef] [PubMed]
- Koksharova, O.A.; Butenko, I.O.; Pobeguts, O.V.; Safronova, N.A.; Govorun, V.M. β-N-methylamino-L-alanine (BMAA) causes severe stress in Nostoc sp. PCC 7120 cells under diazotrophic conditions: A proteomic study. Toxins 2021, 13, 325. [Google Scholar] [CrossRef]
- Lee, C.S.; Park, M.H.; Kim, S.H. Selection and characterization of probiotic bacteria exhibiting antiadipogenic potential in 3T3-L1 preadipocytes. Probiotics Antimicrob. Proteins 2022, 14, 72–86. [Google Scholar] [CrossRef]
- Jaglin, M.; Rhimi, M.; Philippe, C.; Pons, N.; Bruneau, A.; Goustard, B.; Daugé, V.; Maguin, E.; Naudon, L.; Rabot, S. Indole, a signaling molecule produced by the gut microbiota, negatively impacts emotional behaviors in rats. Front. Neurosci. 2018, 12, 216. [Google Scholar] [CrossRef] [PubMed]
- Li, Q.q.; Zeng, S.p.; Liang, M.h.; Yousaf, M.; Wu, Y.p.; Tang, J.; Xiong, J.; Liu, D.m. Safety and metabolism characteristics of Lacticaseibacillus rhamnosus LR-ZB1107-01 based on complete genome and corresponding phenotype. LWT 2024, 204, 116443. [Google Scholar] [CrossRef]
- Lee, D.Y.; Seo, Y.S.; Rayamajhi, N.; Kang, M.L.; Lee, S.I.; Yoo, H.S. Isolation, characterization, and evaluation of wild isolates of Lactobacillus reuteri from pig feces. J. Microbiol. 2009, 47, 663–672. [Google Scholar] [CrossRef] [PubMed]
Disclaimer/Publisher’s Note: The statements, opinions and data contained in all publications are solely those of the individual author(s) and contributor(s) and not of MDPI and/or the editor(s). MDPI and/or the editor(s) disclaim responsibility for any injury to people or property resulting from any ideas, methods, instructions or products referred to in the content. |
© 2025 by the authors. Licensee MDPI, Basel, Switzerland. This article is an open access article distributed under the terms and conditions of the Creative Commons Attribution (CC BY) license (https://creativecommons.org/licenses/by/4.0/).